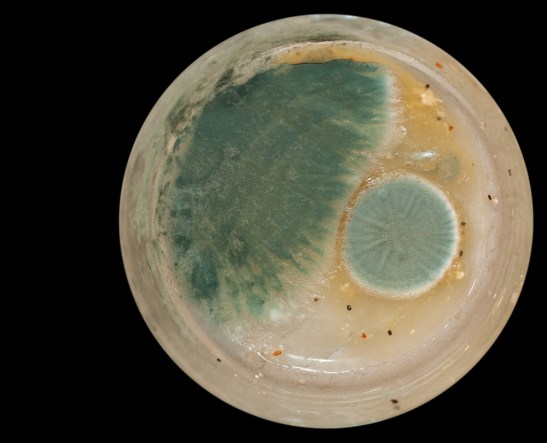

Planet Mold
Look at this amazing Earth-like planet recently discovered and photographed!
Na, It’s just my wife’s lunch. She left the vestiges of it sitting for days in a round glass container. When I took off the lid, I thought it looked like a Google Earth image, so I photographed it and cropped out all but the contents of the container.
Mold can be beautiful! Such delicate, pastel colors. Life is amazing.